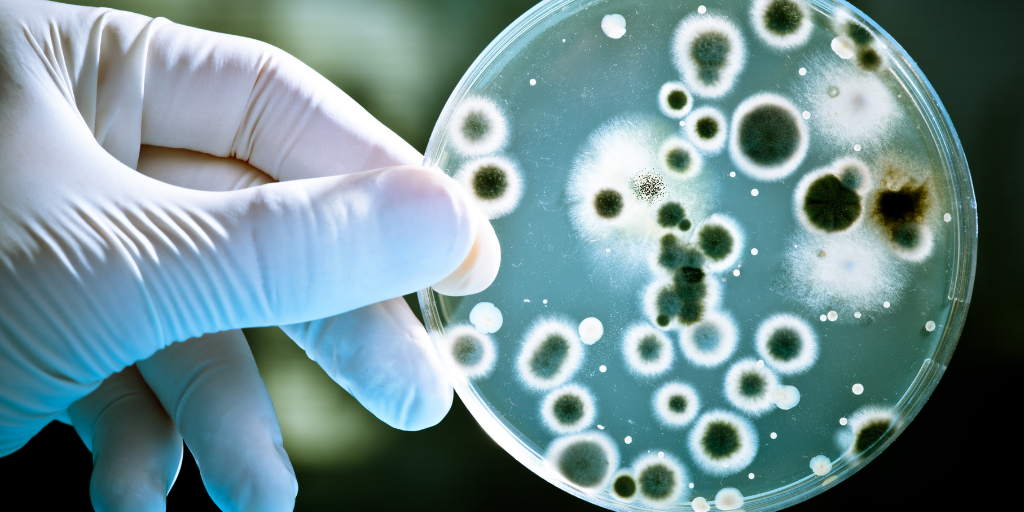

Nuestros profes particulares te proporcionan sus mejores consejos con el Apoyo Escolar
Ya sea que tengás un nivel bajo, querás mejorar tus notas o estés preparándote para un examen en Costa Rica, en Superprof encontrás la ayuda que necesitás con clases particulares adaptadas a vos.
Superprof es la plataforma líder para encontrar clases particulares en Costa Rica, con profes de matemáticas, apoyo escolar, español, lengua y literatura, entre muchas otras materias. Más de 20.000 estudiantes y docentes en el país ya confían en nosotros para mejorar su rendimiento académico.
Explorá los perfiles de nuestros profesores particulares, compará precios y experiencias, y elegí el profe que mejor se adapte a tus objetivos académicos.
📚 El panorama de las asignaturas escolares en Costa Rica
Si estás buscando información clara y actualizada sobre las materias escolares en Costa Rica, en Superprof encontrás todo lo que necesitás para mejorar tus notas y avanzar en tus estudios.
En esta categoría te ofrecemos guías completas sobre las principales asignaturas del sistema educativo costarricense, como matemáticas, español, biología, física y química. También incluimos otras materias que forman parte del aprendizaje académico según el nivel educativo.
Aquí vas a encontrar:
- Explicaciones fáciles de entender
- Tips de estudio adaptados a estudiantes en Costa Rica
- Preparación para exámenes escolares y admisión universitaria
- Orientación sobre salidas académicas y profesionales
Y además, contenido práctico, ejemplos reales y consejos que te ayudarán a estudiar mejor y con más confianza.
🔢 Clases de matemáticas en Costa Rica
Las clases de matemáticas en Costa Rica son de las más buscadas por estudiantes de primaria, colegio y universidad.
Aunque muchos tienen facilidad con los números, es muy común necesitar apoyo escolar en matemáticas para entender mejor los temas y mejorar el rendimiento.
En nuestros artículos vas a encontrar ayuda sobre:
✅ Resolución de problemas paso a paso
✅ Números primos, fracciones y operaciones básicas
✅ Teorema de Pitágoras explicado fácil
✅ Geometría: figuras, áreas y volúmenes
✅ Operaciones combinadas (suma, resta, multiplicación y división)
También abordamos:
- Sistema métrico decimal
- Tablas de multiplicar
- Manejo del tiempo
- Técnicas de estudio para matemáticas
👉 Si buscás clases particulares de matemáticas en Costa Rica, en Superprof podés encontrar profes que se adaptan a tu nivel y objetivos.
✍️ Clases de español (lengua) en Costa Rica
El español (lengua) es clave en la educación costarricense, ya que permite desarrollar habilidades de comunicación, comprensión y expresión.
En esta sección vas a aprender:
- Ortografía y gramática
- Redacción y comprensión de lectura
- Ampliación de vocabulario
- Técnicas para exposiciones y expresión oral
👉 También podés encontrar clases particulares de español en Costa Rica para mejorar tu rendimiento o prepararte para exámenes.
⚡ Clases de física en Costa Rica
La física te ayuda a entender cómo funciona el mundo:
- Movimiento de los objetos
- Energía
- Luz y sonido
En nuestros contenidos explicamos desde lo más básico hasta temas más avanzados, con ejemplos prácticos y fáciles de aplicar.
👉 Si necesitás apoyo, podés tomar clases de física en Costa Rica con profes especializados.
🧪 Clases de química en Costa Rica
La química está presente en todo: desde el aire que respirás hasta los productos que usás todos los días.
Aprendé con nosotros:
- Estructura de la materia
- Reacciones químicas
- Conceptos básicos y avanzados
👉 Encontrá clases particulares de química en Costa Rica y mejorá tu comprensión paso a paso.
🌱 Clases de biología en Costa Rica
La biología estudia a los seres vivos y el entorno natural.
En esta sección vas a descubrir:
- El cuerpo humano
- Genética
- Ecosistemas
👉 Ideal si necesitás apoyo escolar en biología o querés prepararte mejor para tus exámenes.
🏛️ Latín y otras materias
Aunque no es tan común, el latín sigue siendo útil para entender el origen del español y otras lenguas romances.
También puede servirte si te interesa:
- Historia
- Literatura
- Idiomas